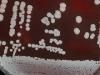

Measured and unmeasured costs can have a significant impact on outcomes for patients with cancer.

Measured and unmeasured costs can have a significant impact on outcomes for patients with cancer.

A new study conducted by researchers at Kaiser Permanente has found that a considerable number of working-age adults who survive cancer and its toxic treatments, end up with substantial medical debts or declare bankruptcy.

Treatment shows the potential to turn metastatic breast tumors into low-grade tumors.

Study finds adoption of Medicaid expansion could reduce disparities in breast cancer screening.

Palbociclib has been found effective inhibiting the mobilization of enzymes that contribute to the rapid division of tumor cells.

Research may lead to new treatment approach for cancer.

Revenue not expected to maintain pace of current immunology treatments.

Severity and type of symptoms varies among cancer patients in different age groups.

Out-of-pocket costs to remain a significant hurdle for patients even after closing of coverage gap.

Vistogard treats patients who develop life-threatening toxicities within days of receiving cancer drugs.

Chemosensitivity, treatment variations, and socioeconomic factors may be a significant factor.

Defective DNA repair mechanisms may contribute to Alzheimer's disease.

Researchers confirm antidepressants do not cause recurrence in breast cancer patients treated with tamoxifen.

Hormone treatment may prove to be effective alternative option for patients with invasive lobular carcinoma.

Patients with cancer see a decline in employment, hours worked, individual income, and total family income following diagnosis.

Newly discovered pathway may prove effective target for treatment of triple-negative breast cancer.

Terms like revolutionary or miracle cause confusion for readers.
Study may lead to enhanced efficacy of breast cancer drugs.

Blood test offers insight into how well a drug is working during the course of cancer treatment.

Non-Hispanic whites more likely to be diagnosed with less advanced stages of breast cancer.

Accelerated partial breast irradiation reduces therapy into just 5 days.

Women increasingly choosing surgery to remove both breasts.

Breast Cancer and the Environment Research Program will focus on racially and ethnically diverse communities and expand the study of risk factors.

Gel may eventually eliminate the need for animal testing in medical research.

Process makes tumors more sensitive to chemotherapy to improve targeted therapy.